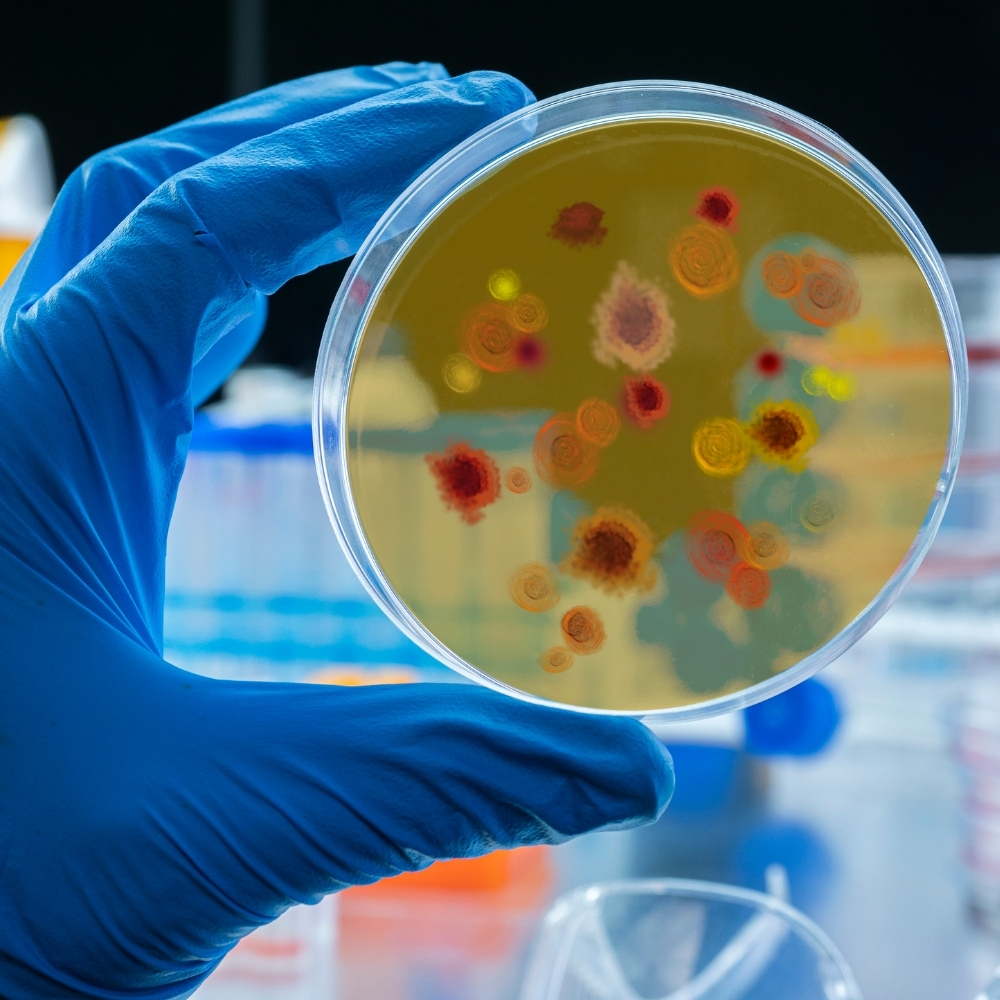

- Vishalakshi Nagar, Visakhapatnam, Andhra Pradesh 530043
- srivishnuhospital22@gmail.com
- +91 9346156332, +91 8790724270
General Treatments
View All General Services Available Here

Our Service
Your General Physician Knows Everything

Cold, Cough, Viral Fever
Diagnosis and treatment of common respiratory infections such as cold, cough, and viral fever, focusing on symptom relief and recovery.
Influenza, Typhoid, Dengue, Malaria
Comprehensive management of infectious diseases like influenza, typhoid, dengue, and malaria, including diagnosis, treatment, and prevention strategies.

Respiratory Illness, Infectious Disease
Expert care for a wide range of respiratory illnesses and infectious diseases, tailored to each patient's specific condition and needs.

Allergies and Asthma
Diagnosis and management of allergies and asthma, including personalized treatment plans to alleviate symptoms and improve quality of life.

Blood Pressure and Obesity
Monitoring and management of blood pressure and obesity, incorporating lifestyle modifications and medical interventions to promote cardiovascular health.

Thyroid Treatment, Sinus Infection
Treatment and management of thyroid disorders and sinus infections, addressing underlying causes and alleviating symptoms.

Complete Diabetes Management
Comprehensive care for diabetes, including monitoring, medication management, lifestyle counseling, and complication prevention.

Hypertension
Diagnosis and treatment of hypertension (high blood pressure), focusing on lifestyle changes and medication to control blood pressure and reduce cardiovascular risk.

Kidney Diseases
Evaluation and management of kidney diseases, including chronic kidney disease, kidney stones, and urinary tract infections.

Urinary Tract Infections
Diagnosis and treatment of urinary tract infections (UTIs), utilizing antibiotics and supportive therapies to alleviate symptoms and prevent complications.

Anaemia
Diagnosis and treatment of anaemia, including identifying underlying causes and implementing appropriate interventions to restore healthy blood levels.

Pyrexia of Unknown Origin
Investigation and management of fever of unknown origin, utilizing diagnostic tests and specialized care to identify underlying causes.

Gastrointestinal Infections
Diagnosis and treatment of gastrointestinal infections, including bacterial, viral, and parasitic infections affecting the digestive system.

Migraine, Headache
Evaluation and management of migraine and headache disorders, incorporating lifestyle modifications and medication to alleviate symptoms and improve quality of life.

Ear, Nose, Throat (ENT) Infections
Diagnosis and treatment of ear, nose, and throat infections, including otitis media, sinusitis, and tonsillitis.
Testimonials
What Clients Say About Us
Pellentesque a quam vitae ligula porttitor luctus.
Aliquam fringilla nibh nec erat rhoncus, at sodales orci mattis. Vestibulu ante ipsum primis in faucibus orci luctus et ultrices posuere cubilia erp curae Cras volutpat fermentum ligula.

Weston R. James
Dental Patient
Aliquam fringilla nibh nec erat rhoncus, at sodales orci mattis. Vestibulu ante ipsum primis in faucibus orci luctus et ultrices posuere cubilia erp curae Cras volutpat fermentum ligula.

Maria D. Crozier
Pregancy Patient


